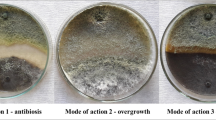

Abstract
Colletotrichum nymphaeae is the principal causal agent of strawberry anthracnose worldwide, including Iran. For disease management, eco-friendly alternatives such as biological control instead of chemical fungicides are highly desirable. The aim of this study was to compare the efficacy of 20 strains of Trichoderma spp. indigenous to Iran against C. nymphaeae, to a commercial strain of Trichoderma atroviride (SC1) isolated elsewhere, under in vitro and in planta conditions. The tested strains belonged to T. harzianum (ten isolates), T. pleuroticola (five isolates), T. virens (three isolates), T. asperellum (one isolate) and T. afroharzianum (one isolate). In vitro results showed that most isolates used in this study were able to significantly inhibit mycelial growth of the pathogen in dual culture and non-volatile tests. The majority of the tested Trichoderma spp. isolates produced lytic enzymes, including chitinase, β-1,3-glucanase, protease and cellulase. Besides producing hydrogen cyanide, Trichoderma spp. strains were also shown to be positive in terms of siderophore production and the mycoparasitism process. In planta bioassays revealed that the best indigenous strain (T. virens CCTUT4) significantly reduced anthracnose, at the same rate as the commercial strain, although the standard chemical fungicide (Switch®) was superior in terms of disease control. A positive correlation between disease incidence and severity reduction was detected with increasing population density of the antagonists in this study. The findings of this study indicate that isolating Trichoderma-based biocontrol agents from the crop against whose disease are targeted does not necessarily provide advantages in comparison with a strain having good biocontrol properties and originating from a different substrate.
Similar content being viewed by others
Avoid common mistakes on your manuscript.
Introduction
The fruit of the cultivated strawberry (Fragaria × ananassa Duch.) is highly appreciated because of its taste, red colour grace and high antioxidant content [1, 2]. Fungal pathogens are responsible for an extensive reduction in the quality and quantity of strawberries, both pre-harvest and post-harvest [3]. Anthracnose disease, caused by Colletotrichum spp., is a serious threat for the strawberry industry worldwide [4, 5]. Recent phylogenetic studies have revealed that at least twelve species belonging to complex species of both C. acutatum and C. gloeosporioides can cause anthracnose symptoms on the strawberry [6,7,8]. Colletotrichum fragariae, which is one of the main pathogens causing strawberry anthracnose, is now considered synonym to C. theobromicola in C. gloeosporioides sensu lato [8]. Of the species involved in strawberry anthracnose, C. nymphaeae (a member of C. acutatum sensu lato) is the most widespread and aggressive [6, 9, 10]. It seems to be the dominant pathogen of strawberry anthracnose in the majority of growing regions, including Iran [10].
Several approaches are currently applied to control strawberry anthracnose, including agronomic practices, use of resistant cultivars and chemical plant protection, individually or combined [11]. Although synthetic fungicides are highly effective, their negative environmental drawbacks, development of pathogen-resistant strains and increasing demand for sustainable agriculture are stimulating the adoption of alternative approaches such as biological control with microbial biopesticides. To date, few attempts have been made to evaluate the biocontrol potential of different micro-organisms against strawberry anthracnose. Biocontrol potential of various Trichoderma species on strawberry anthracnose has been evaluated under laboratory and greenhouse conditions [12, 13]. Application of commercial Trichoderma strains namely T. harzianum T-39, T. hamatum T-105, T. atroviride T-161 and T. longibrachiatum T-166 have significantly reduced anthracnose disease caused by C. acutatum sensu lato in a large scale experiment [14]. In an another study, two commercial fungal biocontrol agents, Prestop (Gliocladium catenulatum) and PlantShield (Trichoderma harzianum), each reduced anthracnose development over the two years experiment by up to 45% when sprayed three times onto plants between flowering and fruit ripening [15]. In field assessment, during three consecutive growing seasons, Trichoderma application reduced anthracnose disease incidence, and consequently plant mortality [16]. The results of these studies indicate that Trichoderma strains are appropriate candidates for biological control of strawberry anthracnose. Trichoderma spp. have received increasing attention from scientists as biocontrol agent for several diseases. In recent years, numerous Trichoderma spp. strains have been formulated and are commercially available such as Canna AkTRIvator®, Trichosan®, Vitalin®, Promot® WP [17]. Accordingly, Trichoderma atroviride SC1, as a commercial biofungicide against esca disease on grapevine, was initially isolated in Italy from decayed hazelnut wood and developed worldwide. It is active against several pathogens including Armillaria mellea, Phaeomoniella chlamydospora and Phaeoacremonium aleophilum [18, 19].
In previous studies, a variable level of biocontrol efficacy of Trichoderma spp. strains against strawberry anthracnose has been reported [13, 14, 16]. One of the hypotheses for such inconsistency could be the low level of adaptation of strains when applied on a crop different form the one where the strains have been isolated. In fact, it has already been noted that the efficacy of biological control agents (BCAs) against plant pathogens and their effect on plant growth and yield depend on plant species and cultivars [20] and that indigenous agents are considered to be more ecologically adaptable particularly in interaction with other micro-organisms and plant exudates [21]. In addition, none of the previous studies addressed the variability of indigenous Trichoderma spp. strains in a location/region to assess the natural degree of biocontrol within this genus in a specific area. The objective of this study was thus to explore the biological variability of indigenous Trichoderma isolates inhabiting strawberry plants in a region and their effect against C. nymphaeae causing strawberry anthracnose, in comparison with a commercial strain isolated elsewhere. This commercial strain was selected to compare with Trichoderma isolates in this study, in terms of its biocontrol mechanisms and efficacy in controlling C. nymphaeae under in vitro and in planta conditions.
Materials and methods
Micro-organisms
Eighteen Trichoderma spp. isolates were obtained from the strawberry rhizosphere and deposited in the culture collection of Kurdistan University, Kurdistan, Iran, and two isolates (CCTUTK1 and CCTUTK2) were isolated from the strawberry leaf surface. A commercial biofungicide strain (T. atroviride SC1; Vintec, Belchim crop protection) was used for comparison in all the tests. Colletotrichum nymphaeae CCTUCCh32 strain, isolated from strawberry fields in Kurdistan [22], was used as the pathogen strain in all trials. Besides T. atroviride SC1, isolated from decayed hazelnut wood in Italy, the rest of isolates including Trichoderma isolates and C. nymphaeae CCTUCCh32 were obtained from strawberry fields in Kurdistan province (west of Iran). Single spore culture was established for all Trichoderma isolates in this study using the method described by Arzanlou et al. [23]. Pure cultures were transferred onto slant homemade potato carrot agar (PCA; potatoes, 20 g; carrots 20 g; agar 15 g and sterile distilled water to a final volume of 1000 ml) and stored at length at 4 °C in the Culture Collection of Tabriz University (CCTU).
DNA extraction, amplification and sequencing of Trichoderma isolates
Total genomic DNA was extracted from the pure culture of each isolate with a 96-well Soil DNA isolation kit (MO BIO Laboratories, USA) according to the manufacturer’s instructions. The DNA concentration in the samples was measured with a NanoDrop nd-1000 spectrophotometer (NanoDrop Technologies, USA), and dilutions were then made. In polymerase chain reactions, the primer pairs of ITS1 and ITS4 [24] were used to amplify partial regions of ribosomal DNA. Each PCR was adjusted to a final volume of 25 μl. The reaction mixture consisted of 50 ng genomic DNA, 1X Dream Taq Green, PCR Mastermix (Fer-mentas, Lithuania) and 0.2 μM of each primer. The PCR mixture was subjected to initial denaturation at 95 °C for 5 min and followed by 35 cycles, 1 min at 94 °C, 30 s at 52 °C and 1 min at 72 °C, with a final extension of 7 min at 72 °C. PCR products were separated on 1% agarose gel stained with ethidium bromide, and their length was estimated in comparison with the Gene Ruler molecular marker (GeneRuler™, #SM0241). For sequencing, PCR products were purified with Exo-Sap enzyme (Euroclone S.p.A., Italy) according to the manufacturer’s instructions and sequenced using a BigDye® Terminator v3.1 Cycle Sequencing Kit (Applied Biosystems, USA).
ITS phylogeny
Staden package program version 2.0.0 software was used to assemble and correct raw trace files obtained from both forward and reverse directions [25]. Using preliminary blasting, sequences similar to those of the isolates in this study and ex-type and ex-epitype strains of each species were downloaded from NCBI’s GenBank database (Supplementary Table 1) and aligned using the MUSCLE program implemented in the MEGA 6 [26]. In phylogenetic analysis, all gaps and characters were treated as missing data and equal weight, respectively. The best-fit evolutionary model for the aligned dataset was identified using the software MrModelTest v. 2.3 [27]. Bayesian inference (BI) analysis of ITS phylogeny was performed using MrBayes v. 3.2.1 [28]. The heating parameter was set at 0.15. Markov Chain Monte Carlo (MCMC) analysis of four chains was run from random trees for 1,000,000 generations, and trees were sampled every 1000 generations. The first 25% of saved trees were discarded as the burn-in phase of the analysis. Consensus tree and posterior probability (PP) were determined from the remaining trees. During phylogenetic analysis, Protocrea pallida (CBS 299.78) served as the out-group taxon [29].
Dual culture assay
In order to evaluate the antagonistic ability of Trichoderma spp. strains against C. nymphaeae strain CCTUCCh32 a dual culture assay was set up. Five-day-old cultures of the Trichoderma spp. strains were prepared on potato dextrose agar (PDA; Sigma-Aldrich, UK). Mycelial plugs (5 mm diameter) of C. nymphaeae were taken from 10-day-old cultures using a sterile cork borer and placed on one side of the Petri dishes (8 cm) on PDA 0.5 mm from the border 5 days earlier, reflecting slow growth of the pathogen. Similar plugs were taken from the Trichoderma spp. strain cultures and placed on the opposite side to the pathogen at the same distance from the border. Three replicates (Petri dishes) were prepared for each Trichoderma spp. strain. Petri dishes were incubated at 25 °C for 10 days. Petri dishes inoculated only with the pathogen were used as control. The inhibition percentage was calculated using the following formula: (C − T n )/C × 100, where C is the colony radius in the control and T n is the colony radius of the pathogen in each treatment [11].
Microscopic examination of the antagonist–pathogen interaction
In order to examine the morphological reaction of the pathogen’s vegetative organs in interaction with the antagonists, mycelial plugs at the place of contact between the pathogen and antagonists on PDA were removed and examined, after placing a drop of lacto phenol on them, and photographs were taken under an optical microscope at × 100 magnification.
Non-volatile toxic compounds
A sterile cellophane membrane (0.2-µm thick) was placed on the PDA surface in the Petri dishes, and a mycelial plug (5 mm) of each Trichoderma spp. strain was placed in the centre to allow the metabolites to spread in the medium, but avoiding fungal growth in the medium. After 48 h, the membrane with the fungus was removed, and the middle of each plate was inoculated with a pathogen mycelial plug (5 mm). All plates were incubated at 25 °C for 10 days. Non-treated PDA was inoculated with the pathogen in the same way and served as a control. Three replicates per each Trichoderma spp. strain were prepared. Inhibition percentage was calculated based on the above-mentioned formula [30], but considering the diameter of the colonies instead of the radius.
Volatile toxic compounds
Petri dishes containing PDA were inoculated with a mycelial plug (5 mm) of each Trichoderma spp. strain. After 3 days of incubation at 25 °C, each of the inoculated Petri dishes was placed face-to-face with Petri dishes inoculated with the pathogen. Both half plates were firmly sealed with parafilm to prevent any loss of volatile compounds. As a control, Petri dishes with non-inoculated PDA plugs were used. The plates were maintained at 25 °C for 10 days. Three replicates for each Trichoderma spp. strain were prepared. Inhibition percentage was then calculated, based on the above-mentioned formula [31].
Enzyme activities assay
To assess protease activity, Trichoderma spp. strains were cultured on skim milk agar (4 g skim milk, 1 g mycological peptone, 5 g NaCl, 15 g agar (all from Sigma-Aldrich) and 1000 ml distilled water) as described by Karimi et al. [32]. Protease activity was assessed as the ability to create a clear zone around colonies on skim milk agar. Water-inoculated skim milk agar was used as a control.
To assess β-1,3-glucanase activity, carboxymethylcellulose (CMC) agar (1 g NH4H2PO4, 0.2 g KCl, 1 g MgSO4, 1 g yeast extract, 15 g agar and 1000 ml distilled water) was used, as modified by Kasana et al. [33], by replacing CMC with laminarin (Sigma-Aldrich, UK). After solidification, a 5-mm plug of 5-day-old Trichoderma spp. culture was taken with a cork borer (6 mm) and placed in the middle of the Petri dish. Petri dishes were incubated at 25 °C for 3 days. Enzymatic activity on the plates was observed by dipping in Gram’s Iodine dye (2.0 g KI and 1.0 g iodine in 300 ml distilled water) for 15–20 min, followed by destaining with 1 N NaCl and then with 1 N NaOH for 15 min. The destaining was repeated. β-1,3-glucanase activity was recorded as the size of the clearance zone.
To assay the cellulase activity, Czapek-mineral salt agar medium (2 g NaNO3, 1 g K2HPO4, 0.5 g MgSO4.7H2O, 0.5 g KCl, 2 g peptone, 20 g agar and 1000 ml distilled water) amended with 5 g CMC was used [33]. Petri dishes were inoculated in the middle with 5-mm plugs of each Trichoderma spp. cultures and incubated at 25 °C in an inverted position. After 5 days, a total of 10 ml of 1% aqueous solution of hexadecyltrimethyl ammonium bromide was added on the surface of each Petri dish. The size of the clearance zone around the colony was measured to assess cellulase activity.
To assay the chitinase activity, colloidal chitin was initially obtained from the C. nymphaeae strain CCTUCCh32 cell wall as described by Monreal and Reese [34]. The chitinase detection medium contained 4.5 g colloidal chitin, 0.3 g MgSO4, 3.0 g (NH4)2SO4, 2.0 g KH2PO4, 1.0 g citric acid monohydrate, 15 g agar, 0.15 g bromocresol purple and 200 μl of tween 80 per litre. The pH of the media was adjusted to 4.7 with KOH. After medium gelification, the centre of each Petri dish was inoculated with a 5 mm disc of Trichoderma spp. strains and incubated at 25 °C for 3 days. Formation of the purple colour zone indicates chitinase production [35].
Hydrogen cyanide
Production of hydrogen cyanide was determined on PDA [36]. The upper lids of Petri dishes were filled with sterilised filter paper and then soaked with 2.0% Na2CO3 in 5.0% (w/v) picric acid. The middle of the underlying Petri dishes containing PDA was inoculated with a 5 mm plug of Trichoderma spp. strains. The Petri dishes were sealed with parafilm and incubated at 25 °C for 4 days. Non-treated PDA was considered as control. A change in the colour of the filter paper from yellow to reddish brown was considered to show hydrogen cyanide production.
Siderophore production
Chromazurol S-blue agar was prepared according to Schwyn and Neilands [37], with some modifications. Initially two separate solutions were prepared: solution 1 consisted of 15.3 mg CromoAzurol S dissolved in 12.5 ml ddH2O, mixed with 10 ml iron (III) solution (1 Mm FeCl·6H2O, 10 mM HCl) and while stirring, slowly added to CTAB (18.23 mg) dissolved in 10 ml ddH2O. The resultant dark blue liquid was autoclaved at 121 °C for 15 min; solution 2 consisted of two separately prepared solutions mixed together (7.56 g Pipes in 187.5 ml ddH2O and 1.5 g NaOH in 1.5 ml ddH2O). The pH of solution 2 was adjusted to 6.8 with KOH and autoclaved, after adding 3.5 g agar. Finally, solution 1 was added to solution 2, and the resultant lukewarm medium was poured into the plates. After solidification, the medium was cut into two halves, one of which was replaced with malt extract agar (2%) (MEA, sigma-Aldrich). The halves containing MEA were inoculated with Trichoderma spp. strains. The plates were incubated for 2 weeks at 25 °C in the dark. A colour change in the green-agar was considered to show siderophore production.
Biocontrol and persistence evaluation of antagonists in interaction with C. nymphaeae on strawberry leaves
Of the isolated strains, T. virens CCTUT4 was selected based on in vitro tests to assess its potential in terms of disease incidence and severity reduction on leaves. In the in planta trial, the efficacy of T. virens CCTUT4 was compared to the commercial reference strain (T. atroviride SC1), and the fungicide Switch® 62.5 WG (active substance: 37.5% cyprodinil + 25%; fludioxonil, Syngenta Agribusiness, Switzerland) used at a concentration of 3 g l−1 against C. nymphaeae strain CCTUCCh32. Strawberry leaves of the same size and age were taken from healthy plants. All leaves were disinfected in 1% hypochlorite and 70% alcohol for 30 s, washed three times in sterile distilled water and dried under a laminar flow hood. The inoculum concentration of the two Trichoderma strains was initially adjusted to 1 × 106 conidia ml−1. Using this suspension, dilution series of 1 × 105 and 1 × 104 conidia ml−1 were then made. The antagonists, along with the fungicide, were initially sprayed on leaves with a hand sprayer (300 μl). Treated leaves were kept on humid sterile paper in large plastic Petri dishes (15 cm diameter) at room temperature. After 24 h, the pathogen inoculums at concentration of 1 × 106 conidia ml−1 were sprayed onto the leaf surface with a hand sprayer (300 μl). Water-treated and pathogen only inoculated leaves served as the negative and positive controls, respectively. After 7 days, all the leaves were frozen for 1–2 h at −15 °C, then disinfested in 0.525% NaOCL for 1 min and rinsed once in sterile distilled water for 1 min [38]. Afterwards, all leaf samples were left at room temperature for 7 days in new Petri dishes. Disease incidence was assessed as the percentage of infected leaves, and the disease severity rate was measured as the percentage of infected leaf surface area using imageJ ver. 1.51i software (https://imagej.nih.gov/ij/index.html). Five replicates per treatment were carried out.
In the meantime, the persistence of the two selected antagonists, T. virens CCTUT4 and T. atroviride SC1 was assessed on strawberry leaves when inoculated individually in interaction with the pathogen inoculums as stated above. After application of the selected strains to the leaf surface, leaf samples were taken 48, 96 and 144 h after inoculation. The leaves were blended, and 1 g of the sample was suspended in 10 ml of sterile distilled water containing Tween 80 (0.1% v/v) and shaken with 0.5 g glass beads (0.6–0.8 mm diameter) for 1 min in a vortex at maximum speed. The Trichoderma sp. population was determined by dilution plating on Trichoderma semi-selective medium [39] and expressed as colony forming units (CFUs) g−1 of leaf.
Data analysis and statistics
All experiments were carried out twice. Unless otherwise mentioned, all experiments were carried out with three replicates for each strain/treatment. In vitro data were analysed using one-way ANOVA. Two-way ANOVA was used on data obtained from in planta analysis. The means were compared with the least significant difference (LSD) test. The Pearson correlation test was used to establish correlation between in vitro tests. Data were analysed with SAS software (SAS institute, Inc. USA, 2003).
Results
Molecular identification
The final aligned ITS dataset contained 34 taxa (33 in-group taxa) with a total of 535 characters, containing 94 unique site patterns. MrModeltest 2.3 software recommended the Kimura 2-parameter substitution model with Gamma distribution as the best model for the ITS dataset. Based on ITS phylogeny, the twenty Trichoderma spp. isolates in this study resided in two main clades with high posterior probability (Fig. 1) including ex-type and ex-epitype strains of each species. The first clade belonging to T. asperellum included the CCTUT22 isolate in this study, and the second clade included five monophyletic subclades. Based on these subclades, three isolates (CCTUT4, CCTUT14, CCTUT20) resided in subclade 1 (T. virens), five isolates (CCTUT5, CCTUT10, CCTUT21, CCTUT24, CCTUT26) in subclade 2 (T. pleuroticola), the isolate of CCTUT18 in subclade 3 (Hypocrea lixii/T. harzianum), the isolate of CCTUT1 in subclade 4 (T. afroharzianum) and the nine isolates (CCTUTK1, CCTUTK2, CCTUT2, CCTUT9, CCTUT11, CCTUT12, CCTUT16, CCTUT17, CCTUT19) in subclade 5 (T. harzianum) (Fig. 1).
Dual culture test, non-volatile and volatile compound assays
In dual culture assay, all Trichoderma spp. strains significantly (df = 21; F = 821.13; p < 0.0001) inhibited radial mycelial growth of the pathogen compared with the control. The inhibition ranged from 50 to 61.3% (Table 1). One strain of T. harzianum (CCTUT18) and T. afroharzianum (CCTUT1) had the highest inhibition with 61.3 and 60.4%, respectively (Table 1). In this test, all strains belonging to T. harzianum and T. asperellum CCTUT22 overgrew the pathogen colony compared with other strains (Fig. 2).
In non-volatile compound production, water-soluble compounds exuded by Trichoderma spp. strains in agar significantly (df = 21; F = 149.99; p < 0.0001) reduced the diameter of mycelial growth of the pathogen compared with the control (Table 1). The highest inhibition percentage belonged to T. virens CCTUT4 and T. virens CCTUT20, with 77.91 and 72.08%, respectively, showing a significant inhibition percentage compared with the other strains (Table 1). In this test, two strains of T. harzianum CCTUTK1 and CCTUTK2 had no significant difference compared with the control (Table 1).
In volatile compound assay, the majority of Trichoderma spp. strains significantly reduced (df = 21; F = 4.29; p < 0.0001) the diameter of mycelial growth of the pathogen compared with control (Table 1). However, inhibition mean in this test was much lower than for the two dual culture and non-volatile compounds assay tests (Table 1), so some strains had no significant difference compared with the control (Table 1).
Microscopic examination of the pathogen–antagonist interaction
In this test, chlamydospore formation was mostly observed in all dual interactions (Fig. 3b–d), while in the case of T. harzianum CCTUTK1, coiling mycelium formation was seen around the pathogen’s vegetative structures, leading to malformation of the pathogen’s vegetative mycelia (Fig. 3a).
Mycoparasitism and morphological reaction of C. nymphaeae strain CCTUCCh32 in interaction with fungal antagonists on PDA. a Coiling mycelium of T. harzianum CCTUTK1 on the pathogen mycelium. b–d Chlamydospore formation by the pathogen in response to interaction with T. virens CCTUT4, T. asperellum CCTUT22 and T. atroviride SC1, respectively. Scale bars = 10 μm
Enzymes, hydrogen cyanide and siderophore production
Protease production activity was noticed for all Trichoderma isolates except T. afroharzianum CCTUT1 and T. pleuroticola CCTUT26. Three isolates of T. virens CCTUT4, T. virens CCTUT14 and T. virens CCTUT20 had the highest activity in terms of protease production (Table 2). In the 1,3-glucanase production test, the clearance zone was observed around all fungal colonies tested, showing the ability of all Trichoderma isolates to produce 1,3-glucanase (Table 2). In a similar way to the 1,3-glucanase test, after 3 days chitinase production was recorded for all the Trichoderma isolates, the highest enzyme production activity being exhibited by T. virens CCTUT4, T. virens CCTUT14 and T. virens CCTUT20, while the lowest activity by two strains, T. harzianum CCTUT16 and T. harzianum CCTUT17 (Table 2).
In the cellulase test, the majority of Trichoderma isolates, including 13 isolates from twenty isolates, were able to produce enzymes. Of these, T. harzianum strains produced more cellulase (Table 2). None of the Trichoderma isolates assessed in this study were able to produce hydrogen cyanide in comparison with the control. Decolourisation of CAS-blue agar proving siderophore production was observed for the majority of Trichoderma strains, except for two strains of T. virens CCTUT4 and T. atroviride SC1 (Table 2). However, there were some differences between isolates in terms of the type and amount of siderophore production (Table 3; Fig. 4). For example, in contrast with other isolates, the T. asperellum CCTUT22 isolate produced a red colour instead of a yellow colour, showing the production of a different kind of siderophore on CAS-blue agar (Table 2; Fig. 4).
Inhibition percentage against C. nymphaeae on strawberry leaves through antagonism
During in planta evaluation, the effects of population density of the selected fungal antagonisms, the type of antagonist and the interaction effects on anthracnose severity and incidence on strawberry leaves were assessed. ANOVA showed that, unlike disease incidence, the population concentration of the antagonists had a significant effect (df = 2; F = 7.98; p = 0.0006) on the disease severity rate. The use of two strains of Trichoderma at concentrations of 1 × 105 and 1 × 106 conidia ml−1 significantly decreased disease severity (Fig. 5). As regards the effect of all the treatments, they all significantly reduced disease incidence (df = 4; F = 48.2; p < 0.0001) and severity (df = 4; F = 287.11; p < 0.0001). No disease was observed in treatment with the Switch® fungicide (Fig. 5). Multifactorial ANOVA indicated that the interaction effect of the concentrations and treatments with the two strains of Trichoderm was only significant in the case of disease severity (df = 8; F = 3.38; p = 0.0017). There was no significant difference between antagonists at concentrations of 1 × 105 and 1 × 106 conidia ml−1 compared with the Switch® fungicide and uninfected treatments in terms of disease severity reduction (Fig. 5).
Disease severity ( ) and incidence (
) and incidence ( ) (%) reduction of strawberry anthracnose caused by C. nymphaeae strain CCTUCCh32 on leaves treated with Trichoderma spp. and standard fungicide Switch® (SW) compared to untreated control (PC) and untreated uninoculated control (NC). Trichoderma virens CCTUT4 (TVT4) and T. atroviride SC1 (TASC1) were treated at three concentrations (6: 1 × 106 spore ml−1, 5: 1 × 105 spore ml−1, 4: 1 × 104 spore ml−1). Different lowercase (severity) or uppercase letters (incidence) indicate significant differences (Fisher’s LSD test, p < 0.05)
) (%) reduction of strawberry anthracnose caused by C. nymphaeae strain CCTUCCh32 on leaves treated with Trichoderma spp. and standard fungicide Switch® (SW) compared to untreated control (PC) and untreated uninoculated control (NC). Trichoderma virens CCTUT4 (TVT4) and T. atroviride SC1 (TASC1) were treated at three concentrations (6: 1 × 106 spore ml−1, 5: 1 × 105 spore ml−1, 4: 1 × 104 spore ml−1). Different lowercase (severity) or uppercase letters (incidence) indicate significant differences (Fisher’s LSD test, p < 0.05)
The Trichoderma sp. population was monitored at the three concentrations applied and the relevant times and analysed with multifactorial ANOVA. The persistence of T. atroviride SC1 at concentrations of 1 × 104 conidia ml−1 (df = 1; F = 24; p = 0.0001), 1 × 105 conidia ml−1 (df = 1; F = 38.62; p = 0.0006) and 1 × 106 conidia ml−1 (df = 1; F = 90.75; p ≤ 0.0001) was significantly greater than that of T. virens CCTUT4 (Fig. 6a–c). There was also a significant difference between times at the three concentrations of 1 × 104 conidia ml−1 (df = 2; F = 22.17; p ≤ 0.0001), 1 × 105 conidia ml−1 (df = 2; F = 39.74; p ≤ 0.0001) and 1 × 106 conidia ml−1 (df = 2; F = 30.70; p ≤ 0.0001) (Fig. 6a–c). The interaction effect of antagonists and time was also significant for each concentration, including 1 × 104 conidia ml−1 (df = 2; F = 4.5; p = < 0.03), 1 × 105 conidia ml−1 (df = 2; F = 6.88; p = 0.0102) and 1 × 106 conidia ml−1 (df = 2; F = 5.19; p = 0.0238) (Fig. 6). At all the concentrations monitored, the population density of antagonists decreased with the passing of time (Fig. 6a–c).
Population (colony forming unit; CFU) of Trichoderma spp. [T. virens CCTUT4 (TVT4, dotted line) and T. atroviride SC1 (TASC1; solid line)] applied at concentrations of 1 × 106 (a), 105 (b) and 104 (c) spore ml−1 after 48, 96 and 144 h of inoculation in interaction with C. nymphaeae strain CCTUCCh32. Error bars indicate the SEs of means. Different letters indicate significant differences (Fisher’s LSD test, p < 0.05)
Discussion
In this study, we assessed the biological variation of a set of indigenous Trichoderma spp. isolates obtained from the strawberry rhizosphere and phyllosphere in a specific region (Kurdistan, Iran) and their potential in terms of biocontrol mechanism expression and inhibition against C. nymphaeae CCTUCCh32 under in vitro and in planta conditions. It is generally assumed that micro-organisms occupying the rhizosphere are ideal for use as biocontrol agents, as they form a front-line defence for roots against pathogen attack [40]. The Trichoderma genus includes several species with high biocontrol potential, which have received considerable attention regarding their ability to protect plants against pathogenic micro-organisms [41]. The efficacy of different Trichoderma spp. against strawberry anthracnose caused by Colletotrichum spp. has been reported in previous studies [13,14,15,16].
Bayesian inference analysis of the ITS dataset resided Trichoderma isolates in this study in distinct clades, including type strains of each species, with high posterior probability (Fig. 1). It has been noted that ITS1 and ITS2 are very diagnostic and unique for Trichoderma spp. delimitation, with the exception of a few cases either indicative of an unknown allele of a known species, or very likely representing a new species [42]. The majority of Trichoderma spp. (ten isolates) in the current study was identified as T. harzianum, followed by T. pleuroticola (five isolates), T. virens (three isolates), T. asperellum (one isolate) and T. afroharzianum (one isolate). In several studies, T. harzianum has been reported as the dominant species in the rhizosphere of many plants [43,44,45]. Currently, T. harzianum is considered to be a species complex comprising at least 14 species [17]. Trichoderma afroharzianum has recently been described as a cryptic species in T. harzianum species complex such as the two commercial products, T22 and Canna AkTRIvator, which were originally known as T. cf. harzianum, are now assigned to T. afroharzianum [17]. To the best our knowledge, T. afroharzianum from Iran is reported here for the first time.
The majority of Trichoderma spp. strains used in this study showed antagonistic activity against C. nymphaeae in vitro (radial mycelial growth inhibition in dual culture, volatile and non-volatile compound tests). It seems that pathogen inhibition in dual culture is directly proportional to the growth rate of the Trichoderma isolates, and there was no positive correlation between the dual culture test and the other tests, including volatile and non-volatile compounds (Table 3). In the non-volatile test, three strains of T. virens CCTUT4, CCTUT14 and CCTUT20 had the highest inhibition in colony diameter reduction of the pathogen compared with other strains (Table 1). This inhibition is most probably related to exuded antibiotics such as gliotoxin, gliovirin and peptaibols, which have been previously noted for this species [41]. Although there was a significant difference between Trichoderma spp. strains in terms of mycelial growth inhibition compared with the control in volatile compound tests, the inhibition rate was much lower than the two latter tests (Table 1). This was in line with the lack of hydrogen cyanide (volatile compound) production by Trichoderma isolates in this study (Table 2). The control of some plant diseases such as tobacco black root and Fusarium wilt of cucumber has been attributed to hydrogen cyanide production [46, 47]. In one study, the majority of indigenous Trichoderma spp. obtained from the common bean rhizosphere was unable to produce volatile compounds [48].
The better performance of Trichoderma spp. in non-volatile compound tests in this study may also be attributed to leakage of water-soluble hydrolytic enzymes including proteases, chitinases, glucanases and cellulases into the agar medium, which are frequently associated with cell wall-degrading enzymes (CWDEs) [49]. Unlike protease and cellulase production, chitinase and β-1,3-glucanase enzyme production was exhibited by all Trichoderma spp. in this study (Table 2). Lytic enzymes including chitinase, β-1,3-glucanase, protease and cellulase are directly exerted by antagonistic Trichoderma spp. to invade plant pathogens [50]. In several studies cellulase production by different Trichoderma spp. has been noticed as the main mechanism in the suppression of plant pathogens such as Pythium aphanidermatum and C. gloeosporioides [48, 51]. Generally, it seems that the cellulase enzyme plays a prominent role in increasing colonisation of BCAs on plant roots and debris [20]. Similar to the non-volatile compound production test, three strains of T. virens CCTUT4, T. virens CCTUT14 and T. virens CCTUT20 had the highest activity in chitinase production. This correlation was confirmed using the Pearson correlation test (Table 3). This positive correlation was also confirmed between non-volatile compounds and protease (Table 3). It appears that these compounds were effective ingredients in the non-volatile compound production test regarding mycelial growth inhibition of the pathogen.
It is interesting to note that overgrowing on vegetative bodies of the pathogen was only observed for T. harzianum strains and T. asperellum CCTUT22 in this study, showing possible mycoparasitism activity. Accordingly, in direct interaction on PDA, parasiting was seen by T. harzianum CCTUTK1 as coiling mycelium formation around C. nymphaeae hypha (Fig. 3a), while in most cases numerous chlamydospores were produced (Fig. 3b–d). These observations are in agreement with previous studies related to the effect of Trichoderma spp. on the vegetative bodies of different pathogens, including C. gloeosporioides, C. truncatum and C. acutatum [11, 52]. The mycoparasitism process with Trichoderma spp. involves several stages, including attachment to the host lectin, coiling mycelium and appressorium formation, CWDE secretion and assimilation of the cell wall content [41].
Many fungal BCAs are known to have beneficial effects on plant growth enhancement [53]. In the meantime, siderophore expression by these agents acts as a double-edged sword in plant–microbe interaction, because not only can it provide iron in soluble form for plants with an iron deficiency and accordingly improve plant growth, but it can also lead to suppression of pathogenic micro-organisms by depriving them of iron availability [54]. All the antagonists examined in this study showed siderophore production, except T. atroviride SC1 (Table 2). However, it appears that the kind of siderophore produced was different, at least in the case of T. asperellum CCTUT22, which produced a red rather than yellow colour on CAS-blue agar (Fig. 4a–c). In various studies, siderophore production has been shown to be directly involved in the suppression of plant pathogens [55,56,57,58].
Based on in vitro results in dual culture, non-volatile compound, chitinase, glucanase and protease tests (Tables 1, 2), the T. virens CCTUT4 strain was selected as the best candidate for anthracnose reduction on strawberry leaves and compared to a commercial strain (T. atroviride SC1) and the chemical fungicide Switch®. The modified method used in this study found that treatments including T. virens CCTUT4 and T. atroviride SC1 and Switch® significantly reduced anthracnose incidence and severity on strawberry leaves compared to the infected control (Fig. 5). Compared to the infected control, T. virens CCTUT4 decreased disease incidence more significantly than T. atroviride SC1 at concentrations of 1 × 104 and 1 × 106 conidia ml−1 (Fig. 5). However, complete inhibition of disease incidence and severity was observed only when treated with Switch® (Fig. 5), although there was no significant difference between antagonist treatments and Switch® in terms of disease severity at concentrations of 1 × 105 and 1 × 106 conidia ml−1 (Fig. 6). This observation highlights the effect of population concentration on the antagonists’ performance in this study in relation to strawberry anthracnose reduction. In some studies, the efficacy of BCAs against plant pathogens has been reported to be superior, equal or inferior to fungicides [59,60,61,62,63]. The Switch® fungicide was positively evaluated in control of strawberry anthracnose caused by Colletotrichum spp. [64, 65]. As expected, application of a higher population density of antagonists attained a higher inhibition rate (Fig. 5) [40], although the population density gradually decreased during 7-day examination of different concentrations (Fig. 6a–c). This much reduction associated with the population density of Trichoderma spp. in this study may be related to lack of appropriate colonisation on detached leaves due to nutritional limitations in competition with pathogen. However, at the three concentrations examined at the three times, the persistence of the T. atroviride SC1 commercial strain was significantly higher than that of T. virens CCTUT4 (Fig. 6a–c). This observation highlights that the populations of T. atroviride SC1 commercial strain were probably able to proliferate on the leaf surface. The potential viability of T. atroviride SC1 has been highlighted in several studies [66, 67].
Overall, according to in vitro and in planta experiments regarding strawberry anthracnose biocontrol by the Trichoderma spp. strains examined in this study, it was shown that the ability of these agents in terms of pathogen inhibition is probably related to production of CWD enzymes such as chitinase and protease under in vitro conditions. These mechanisms could be also effective in reducing strawberry anthracnose on leaves under in planta conditions.
Although in vitro tests indicated that several indigenous Trichoderma spp. strains, especially T. virens strains, were superior to the T. atroviride SC1 commercial strain in terms of pathogen mycelial growth inhibition and expression of biocontrol mechanisms (Tables 1, 2), in planta assay of the best of them, T. virens CCTUT4, did not differ in relation to T. atroviride SC1 in terms of disease incidence and severity reduction (Fig. 5). These findings indicate that there is a wide variability among isolates and indigenous Trichoderma spp. strains do not necessarily represent a superior source as compared to effective strains isolated elsewhere. However, biotic factors such as the pathogen and its pathotypes, the host plant species, its cultivars and the plant structures affected by the pathogen may also affect the efficiency of micro-organisms as BCAs [14]. This study did not focus on survival in the targeted environment, where native strains may be more efficient in colonisation than strains not adapted to these conditions, so further studies should focus on clarifying this aspect and plant–strain interaction as well.
References
Food and Agriculture Organization (FAO). (2007). http://faostat3.fao.org/download/Q/QC/E.
Wang, S. Y., & Lewers, K. S. (2007). Antioxidant capacity and flavonoid content in wild strawberries. Journal of the American Society for Horticultural Science, 132(5), 629–637.
Mass, J. L. (1998). Compendium of strawberry diseases. St. Paul, MN: APS Press.
Freeman, S., & Katan, T. (1997). Identification of Colletotrichum species responsible for anthracnose and root necrosis of strawberry in Israel. Phytopathology, 87, 516–521.
Howard, C. M., Maas, J. L., Chandler, C. K., & Albregts, E. E. (1992). Anthracnose of strawberry caused by the Colletotrichum complex in Florida. Plant Disease, 76, 976–981.
Damm, U., Cannon, P. F., Woudenberg, J. H. C., & Crous, P. W. (2012). The Colletotrichum acutatum species complex. Studies in Mycology, 73, 37–114.
Han, Y. C., Zeng, X. G., Xiang, F. Y., Ren, L., Chen, F. Y., & Gu, Y. C. (2016). Distribution and characteristics of Colletotrichum spp. associated with anthracnose of strawberry in Hubei, China. Plant Disease, 100(5), 996–1006.
Weir, B. S., Johnston, P. R., & Damm, U. (2012). The Colletotrichum gloeosporioides species complex. Studies in Mycology, 73, 115–180.
Baroncelli, R., Zapparata, A., Sarrocco, S., Sukno, S. A., Lane, C. R., Thon, M. R., et al. (2015). Molecular diversity of anthracnose pathogen populations associated with UK strawberry production suggests multiple introductions of three different Colletotrichum species. PLoS ONE, 10(6), 0129140.
Karimi, K., Babai Ahari, A., Arzanlou, M., Amini, J., Pertot, I., & Rota-Stabelli, O. (2016). Application of the consolidated species concept to identify the causal agent of strawberry anthracnose in Iran and initial molecular dating of the Colletotrichum acutatum species complex. European Journal of Plant Pathology, 147, 375–387.
Živković, S. V., Stojanović, S., Ivanović, Ž., Gavrilović, V., Popović, T. A., & Balaž, J. E. (2010). Screening of antagonistic activity of microorganisms against Colletotrichum acutatum and Colletotrichum gloeosporioides. Archives of Biological Science Belgrade, 62, 611–623.
Elad, Y., Barbul, O., Nitzani, Y., Rav David, D., Zveibil, A., Maimon, M., et al. (2001). Inter- and intra-species variation in bio-control activity. In: Proceedings of the 5th congress of the European foundation of plant pathology (pp. 474–478).
Freeman, S., Barbul, O., Rav David, D., Nitzani, Y., Zveibil, A., & Elad, Y. (2001). Trichoderma spp. for biocontrol of Colletotrichum acutatum and Botrytis cinerea in strawberry. Biocontrol of Fungal and Bacterial Plant Pathogens, IOBC/WPRS Bulletin, 24, 147–150.
Freeman, S., Minz, D., Kolesnik, I., Barbul, O., Zveibil, A., Maymon, M., et al. (2004). Trichoderma biocontrol of Colletotrichum acutatum and Botrytis cinerea and survival in strawberry. European Journal of Plant Pathology, 110, 361–370.
Verma, N., MacDonald, L., & Punja, Z. K. (2006). Inoculum prevalence, host infection and biological control of Colletotrichum acutatum: Causal agent of blueberry anthracnose in British Columbia. Plant Pathology, 55, 442–450.
Porras, M., Barrau, C., & Romero, F. (2009). Influence of Trichoderma and soil solarization on strawberry yield. Acta Horticulture, 842, 389–392.
Chaverri, P., Branco-Rocha, F., Jaklitsch, W., Gazis, R., Degenkolb, T., & Samuels, G. J. (2015). Systematics of the Trichoderma harzianum species complex and the re-identification of commercial biocontrol strains. Mycologia, 3, 558–590.
Pertot, I., Gobbin, D., De Luca, F., & Prodorutti, D. (2008). Methods of assessing the incidence of Armillaria root rot across viticultural areas and the pathogen’s genetic diversity and spatial–temporal pattern in northern Italy. Crop Protection, 27, 1061–1070.
Pertot, I., Prodorutti, D., Colombini, A., & Pasini, L. (2016). Trichoderma atroviride SC1 prevents Phaeomoniella chlamydospora and Phaeoacremonium aleophilum infection of grapevine plants during the grafting process in nurseries. BioControl, 61, 257–267.
Handelsman, J., & Stabb, E. V. (1996). Biocontrol of soilborn plant pathogens. The Plant Cell, 8, 1855–1869.
Narisawa, K., Ohki, K. T., & Hashiba, T. (2000). Suppression of clubroot and Verticillium yellows in Chinese cabbage in the field by the root endophytic fungus, Heteroconium chaetospira. Plant Pathology, 49, 141–146.
Karimi, K., Babai Ahari, A., Weisany, W., Pertot, I., Vrhovsek, U., & Arzanlou, M. (2016). Funneliformis mosseae root colonization affects Anethum graveolens essential oil composition and its efficacy against Colletotrichum nymphaeae. Industrial Crops and Products, 90, 126–134.
Arzanlou, M., Bakhshi, M., Karimi, K., & Torbati, M. (2015). Multigene phylogeny reveals three new records of Colletotrichum spp. and several new host records for the mycobiota of Iran. Journal of Plant Protection Research, 55(2), 198–211.
White, T. J., Bruns, T., & Taylor, J. (1990). Amplification and direct sequencing of fungal ribosomal RNA genes for phylogenetics. In M. A. Innis, D. H. Gelfand, J. J. Sninsky, & J. W. White (Eds.), A guide to molecular methods and applications (p. 482). New York: Academic Press.
Staden, R. (1996). The staden sequence analysis package. Molecular Biotechnology, 5(3), 233–241.
Tamura, K., Stecher, G., Peterson, D., Filipski, A., & Kumar, S. (2013). MEGA6: Molecular evolutionary genetics analysis version 6.0. Molecular Biology and Evolution, 30, 2725–2729.
Nylander, J. A. A. (2004). MrModeltest v2. Program distributed by the author. Uppsala: Evolutionary Biology Centre, Uppsala University.
Ronquist, F., & Huelsenbeck, J. P. (2003). MrBayes 3: Bayesian phylogenetic inference under mixed models. Bioinformatics, 19, 1572–1574.
Jaklitsch, W. M., & Voglmayr, H. (2015). Biodiversity of Trichoderma (Hypocreaceae) in Southern Europe and Macaronesia. Studies in Mycology, 80, 1–87.
Dennis, C., & Webster, J. (1971). Antagonistic properties of species groups of Trichoderma II. Production of volatile antibiotics. Transactions of British Mycological Society, 57, 41–48.
Dennis, C., & Webster, J. (1971). Antagonistic properties of species groups of Trichoderma I. Production of non-volatile antibiotics. Transactions of British Mycological Society, 57, 25–39.
Karimi, K., Amini, J., Harighi, B., & Bahramnejad, B. (2012). Evaluation of biocontrol potential of Pseudomonas and Bacillus spp. against Fusarium wilt of chickpea. Australian Journal of Crop Science, 6(4), 695–703.
Kasana, R. C., Salwan, R., Dhar, H., Dutt, S., & Gulati, A. (2008). Arapid and easy method for the detection of microbial cellulases on agar plates using gram’s iodine. Current Microbiology, 57, 503–507.
Monreal, J., & Reese, E. T. (1969). The chitinase of Serratia marcescens. Canadian Journal of Microbiology, 15, 669–689.
Agrawal, T., & Kotasthane, A. S. (2012). Chitinolytic assay of indigenous Trichoderma isolates collected from different geographical locations of Chhattisgarh in Central India. SpringerPlus, 1(1), 1.
Alstrom, S. (1987). Factors associated with detrimental effects of rhizobacteria on plant growth. Plant and Soil, 102, 3–9.
Schwyn, B., & Neilands, J. B. (1997). Universal chemical assay for the detection and determination of siderophores. Analytical Biochemistry, 160, 46–56.
Mertely, J. C., & Legard, D. E. (2004). Detection, isolation, and pathogenecity of Colletotrichum spp. from strawberry petioles. Plant Disease, 88, 407–412.
Davet, P., & Rouxel, F. (2000). Detection and isolation of soil fungi. In K. T. Kaimoni (Ed.), Soil fungi-laboratory manuals (p. 188). USA: Science Publishers.
Weller, D. M. (1988). Biological control of soil born plant pathogens in the rhizosphere with bacteria. Annual Review of Phytopathology, 26, 379–407.
Benítez, T., Rincón, A. M., Limón, M. C., & Codón, A. C. (2004). Biocontrol mechanisms of Trichoderma strains. International Microbiology, 7, 249–260.
Druzhinina, I. S., Kopchinskiy, A. G., & Kubicek, C. P. (2006). The first 100 Trichoderma species characterized by molecular data. Mycoscience, 47(2), 55–64.
Jiang, Y., Wang, J. L., Chen, J., Mao, L. J., Feng, X.-X., Zhang, C. L., et al. (2016). Trichoderma biodiversity of agricultural fields in east china reveals a gradient distribution of species. PLoS ONE, 11(8), e0160613.
Maina, P. K., Wachira, P. M., Okoth, S. A., & Kimenju, J. W. (2015). Distribution and diversity of indigenous Trichoderma species in Machakos county, Kenya. British Microbiology Research Journal, 9(4), 1–15.
Sariah, M., Choo, C. W., Zakaria, H., & Norihan, M. S. (2005). Quantification and characterisation of Trichoderma spp. from different ecosystems. Mycopathology, 159(1), 113–117.
Stutz, E. W., Défago, G., & Kern, H. (1986). Naturally occurring fluorescent pseudomonads involved in suppression of black root rot of tobacco. Phytopathology, 76(2), 181–185.
Keel, C., Weller, D. M., Natsch, A., Défago, G., Cook, R. J., & Thomashow, L. S. (1996). Conservation of the 2, 4-diacetylphloroglucinol biosynthesis locus among fluorescent Pseudomonas strains from diverse geographic locations. Applied and Environmental Microbiology, 62(2), 552–563.
Kamala, Th, & Indira, S. (2011). Evaluation of indigenous Trichoderma isolates from Manipur as biocontrol agent against Pythium aphanidermatum on common beans. 3 Biotech, 1, 217–225.
Viterbo, A., Haran, S., Friesem, D., Ramot, O., & Chet, I. (2001). Antifungal activity of a novel endochitinase gene (chit36) from Trichoderma harzianum Rifai TM. FEMS Microbiology Letters, 200, 169–174.
Haran, S., Schikler, H., & Chet, I. (1996). Molecular mechanisms of lytic enzymes involved in the biocontrol activity of Trichoderma harzianum. Microbiology, 142, 2321–2331.
de los Santos-Villalobos, S., Guzmán-Ortiz, D. A., Gómez-Lim, M. A., Délano-Frier, J. P., de-Folter, S., Sánchez-García, P., et al. (2013). Potential use of Trichoderma asperellum (Samuels, Liechfeldt et Nirenberg) T8a as a biological control agent against anthracnose in mango (Mangifera indica L.). Biological Control, 64(1), 37–44.
Begum, M. M., Sariah, M., Zainal Abidin, M. A., Puteh, A. B., & Rahman, M. A. (2008). antagonistic potential of selected fungal and bacterial biocontrol agents against Colletotrichum truncatum of soybean seeds. Pertanika Journal of Tropical Agricultural Science, 31(1), 45–53.
Gravel, V., Antoun, H., & Tweddell, R. J. (2007). Growth stimulation and fruit yield improvement of greenhouse tomato plants by inoculation with Pseudomonas putida or Trichoderma atroviride: Possible role of indole acetic acid (IAA). Soil Biology and Biochemistry, 39, 1968–1977.
Leong, J. (1986). Siderophores: Their biochemistry and possible role in the biocontrol of plant pathogens. Annual review of Phytopathology, 24, 187–209.
Dwivedi, D., & Johri, B. N. (2003). Antifungals from fluorescent pseudomonads: Biosynthesis and regulation. Current Science, 12, 1693–1703.
Elad, Y., & Baker, R. (1985). The role of competition for iron and carbon in suppression of chlamydospore germination of Fusarium spp. by Pseudomonas spp. Phytopathology, 75, 1053–1059.
Kloepper, J. W., Leong, J., Teintze, M., & Schroth, M. N. (1980). Pseudomonas siderophores: A mechanism explaining disease-suppressive soils. Current Microbiology, 4, 317–320.
Tortora, M. L., Díaz-Ricci, J. C., & Pedraza, R. O. (2011). Azospirillum brasilense siderophores with antifungal activity against Colletotrichum acutatum. Archives of Microbiology, 193(4), 275–286.
Anand, T., Chandrasekaran, A., Kuttalam, S., Senthilraja, G., & Samiyappan, R. (2010). Integrated control of fruit rot and powdery mildew of chilli using the biocontrol agent Pseudomonas fluorescens and a chemical fungicide. Biological Control, 52(1), 1–7.
Deberdt, P., Mfegue, C. V., Tondje, P. R., Bon, M. C., Ducamp, M., Hurard, C., et al. (2008). Impact of environmental factors, chemical fungicide and biological control on cacao pod production dynamics and black pod disease (Phytophthora megakarya) in Cameroon. Biological Control, 44(2), 149–159.
Gachango, E., Kirk, W., Schafer, R., & Wharton, P. (2012). Evaluation and comparison of biocontrol and conventional fungicides for control of postharvest potato tuber diseases. Biological Control, 63(2), 115–120.
Ilhan, K., & Karabulut, O. A. (2013). Efficacy and population monitoring of bacterial antagonists for gray mold (Botrytis cinerea Pers. ex. Fr.) infecting strawberries. Biological Control, 58, 457–470.
Ponmurugan, P., & Baby, U. I. (2007). Evaluation of fungicides and biocontrol agents against Phomopsis canker of tea under field conditions. Australasian Plant Pathology, 36(1), 68–72.
Peres, N. A., Seijo, T. E., & Turechek, W. W. (2010). Pre-and post-inoculation activity of a protectant and a systemic fungicide for control of anthracnose fruit rot of strawberry under different wetness durations. Crop Protection, 29(10), 1105–1110.
Wedge, D. E., Smith, B. J., Quebedeaux, J. P., & Constantin, R. J. (2007). Fungicide management strategies for control of strawberry fruit rot diseases in Louisiana and Mississippi. Crop Protection, 26(9), 1449–1458.
Savazzini, F., Longa, C. M. O., Pertot, I., & Gessler, C. (2008). Real-time PCR for detection and quantification of the biocontrol agent Trichoderma atroviride strain SC1 in soil. Journal of Microbiological Methods, 73, 185–194.
Longa, C. M. O., Savazzini, F., Tosi, S., Elad, Y., & Pertot, I. (2009). Evaluating the survival and environmental fate of the biocontrol agent Trichoderma atroviride SC1 in vineyards in northern Italy. Journal of applied microbiology, 106(5), 1549–1557.
Acknowledgements
The authors would like to thank the Research Deputy of the University of Tabriz and the EU INNOVA project (FP7-People-2012-IAPP, Grant Agreement 324416).
Author information
Authors and Affiliations
Corresponding author
Electronic supplementary material
Below is the link to the electronic supplementary material.
Rights and permissions
About this article
Cite this article
Karimi, K., Babai Ahari, A., Arzanlou, M. et al. Comparison of indigenous Trichoderma spp. strains to a foreign commercial strain in terms of biocontrol efficacy against Colletotrichum nymphaeae and related biological features. J Plant Dis Prot 124, 453–466 (2017). https://doi.org/10.1007/s41348-017-0088-6
Received:
Accepted:
Published:
Issue Date:
DOI: https://doi.org/10.1007/s41348-017-0088-6